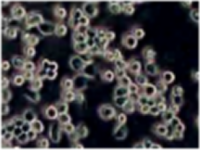
人脐血干细胞

万千商家帮你免费找货
0 人在求购买到急需产品
- 详细信息
- 文献和实验
- 技术资料
- 供应商:
上海烜雅生物科技有限公司
- 库存:
36
- 英文名:
Human Intestinal: Normal Intestinal Mucosa Epithelial Cells
- 运输方式:
常温运输/干冰运输
- 是否是肿瘤细胞:
否
人小肠粘膜上皮细胞提取于正常小肠组织,其主要功能为小肠粘膜上皮细胞分泌肠液,润滑肠管,易于食物向下运动。小肠粘膜上皮皱襞很多,有效扩大小肠吸收面积,易于食物营养的吸收。烜雅生物科技提供的人小肠粘膜上皮原代细胞均来自新鲜组织,用于培养人小肠粘膜上皮原代细胞的组织采集于地方医院,组织的采集根据美国IRB 和 HIPAA批准的方案进行。细胞的培养采用公司专利产品人小肠粘膜上皮细胞培养试剂盒(Human Intestinal PrimaCell™: Normal Intestinal Mucosa Epithelial Cells Cat No. 3-0134)来优化目的细胞生长条件,以降低杂细胞(如脂肪细胞、纤维细胞等)的污染,同时保证质量的稳定。在烜雅生物技术部标准的操作流程下,人小肠粘膜上皮原代细胞可以保持原代细胞的分化状态,进而可以用于评估体外药物模型系统和调节特定基因的遗传功能。
人小肠粘膜上皮细胞使用方法:
1、您收到细胞后,请按照以下方法进行操作:
取出15ml离心管,75%酒精擦拭培养瓶,拆下封口膜,放入37℃,5%CO2细胞培养箱中静置2-3小时以稳定细胞状态,然后离心换用新鲜完全培养液继续培养或进行传代。
2、细胞传代:
待细胞达到一定密度(不超过1x10^6/ml)可按照以下方法换液培养或传代。
方法①:收集细胞,1000rpm离心5min,弃去上清液,补加1-2mL培养液后吹匀,将细胞悬液按1:2到1:3的比例分到新的含8ml培养基的新皿中或者瓶中。
方法②:可选择半数换液方式,弃去半数培养基后,将剩余细胞悬起,将细胞悬液按1:2到1:3的比例分到新的含8ml培养基的新皿中或者瓶中。
3、细胞冻存:
1)将细胞悬液转移至15ml离心管中,1000rpm离心5min;
2)用适量的冻存液(FBS:DMSO=9 :1)重悬细胞,并放置于冻存管中;
3)先将细胞冻存管放置于-20℃ 1.5h,然后将其移入-80℃过夜,24h后转入液氮中进行长期保存。使用程序降温盒可直接放入-80℃。
4、细胞复苏:
1)从液氮中取出细胞冻存管(注意:佩戴防爆管面具),快速将其置入37℃水浴中解冻,直至冻存管中无结晶,然后用75%的酒精擦拭冻存管外壁;
2)将冻存管中的细胞移至含10ml完全培养基的15ml离心管中, 1000rpm离心5min;
3)弃上清,沉淀用5ml完全培养基重悬,接种25cm2培养瓶,于37℃,5%CO2细胞培养箱中培养;
4)第二天,换用新鲜完全培养基继续培养。
风险提示:丁香通仅作为第三方平台,为商家信息发布提供平台空间。用户咨询产品时请注意保护个人信息及财产安全,合理判断,谨慎选购商品,商家和用户对交易行为负责。对于医疗器械类产品,请先查证核实企业经营资质和医疗器械产品注册证情况。
文献和实验柱状上皮主要被覆于鼻腔、鼻咽、支气管树、胃肠、子宫颈管、子宫内膜及输卵管等部位。柱状上皮脱落细胞主要包括涂片纤毛柱状细胞、粘液柱状细胞和储备细胞。 (1)纤毛柱状细胞:细胞呈锥形,顶端宽平,其表面有密集的纤毛,纤毛巴氏染色呈亮红色;胞质泡沫状,巴氏染色染蓝色,HE染淡红色;核圆形位于细胞中部,染色质细颗粒状。在涂片中的常见排列形式: 1)蜂房状排列:细胞成群或呈片医学教育|网搜集整理,排列紧密,不重叠。 2)栅栏状:细胞紧密排列,医学教育|网搜集整理可有重叠
复层鳞状上皮,一般有10多层细胞。被覆于全身皮肤、口腔、喉部、鼻咽的一部分、食道、阴道的全部以及子宫颈。鳞状上皮细胞分为基底层细胞、中层细胞和表层细胞。 (1)基底层细胞 1)内底层细胞:细胞呈圆形或卵圆形,直径12~15μm;胞质巴氏染色呈深蓝、暗绿和灰蓝色,HE染色呈暗红色;胞核圆形或卵圆形,居中,染色质细颗粒状;核与胞质比(即核的直径与细胞质幅缘之比,简称核胞质比)约1:(0.5~1)。 2)外底层细胞:细胞呈圆形或椭圆形,直径15~30μm;胞质较丰富
涂片中脱落的非上皮细胞成分又称背景成分。包括血细胞、粘液、坏死物及异特等。 1.红细胞涂片中可见到多少不等的红细胞。因红细胞大小较恒定,可作为测定其他细胞大小的标尺。红细胞量的多少与病变性质或取材时局部损伤程度有关。 2.中性粒细胞涂片中常可见多量中性粒细胞。中性粒细胞易变性,胞质溶解而成裸核。主要见于组织炎症时。此外见于癌组织坏死后继发感染时。 3.嗜酸性粒细胞其存在与炎症、变态反应或寄生虫感染有关。 4.淋巴细胞见于炎症,特别是慢性炎症时较多
技术资料暂无技术资料 索取技术资料